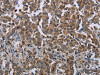
The image on the left is immunohistochemistry of paraffin-embedded Human liver cancer tissue using CSB-PA929004 (HMGCR Antibody) at dilution 1/20, on the right is treated with fusion protein. (Original magnification: ×200)

Cusabio Polyclonal Antibodies
HMGCR Antibody | CSB-PA929004
- SKU:
- CSB-PA929004
- Availability:
- 3 to 7 Working Days
Description
HMGCR Antibody | CSB-PA929004 | Cusabio
HMGCR Antibody is Available at Gentaur Genprice with the fastest delivery.
Online Order Payment is possible or send quotation to info@gentaur.com.
Product Type: Polyclonal Antibody
Target Names: HMGCR
Aliases: 3-hydroxy-3-methylglutaryl-CoA reductase
Background: HMG-CoA reductase is the rate-limiting enzyme for cholesterol synthesis and is regulated via a negative feedback mechanism mediated by sterols and non-sterol metabolites derived from mevalonate, the product of the reaction catalyzed by reductase. Normally in mammalian cells this enzyme is suppressed by cholesterol derived from the internalization and degradation of low density lipoprotein (LDL) via the LDL receptor. Competitive inhibitors of the reductase induce the expression of LDL receptors in the liver, which in turn increases the catabolism of plasma LDL and lowers the plasma concentration of cholesterol, an important determinant of atherosclerosis. Alternatively spliced transcript variants encoding different isoforms have been found for this gene.
Isotype: IgG
Conjugate: Non-conjugated
Clonality: Polyclonal
Uniport ID: P04035
Host Species: Rabbit
Species Reactivity: Human, Mouse, Rat
Immunogen: Fusion protein of human HMGCR
Immunogen Species: Human
Applications: ELISA, IHC
Tested Applications: ELISA, IHC;ELISA:1:1000-1:2000, IHC:1:25-1:100
Purification Method: Antigen affinity purification
Dilution Ratio1: ELISA:1:1000-1:2000
Dilution Ratio2: IHC:1:25-1:100
Dilution Ratio3:
Dilution Ratio4:
Dilution Ratio5:
Dilution Ratio6:
Buffer: -20°C, pH7.4 PBS, 0.05% NaN3, 40% Glycerol
Form: Liquid
Storage: Upon receipt, store at -20°C or -80°C. Avoid repeated freeze.
Initial Research Areas: Cardiovascular
Research Areas: Cancer;Cardiovascular;Metabolism;Signal transduction